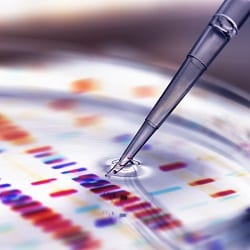
protonclinicaltrials250

How Can You Benefit From Clinical Trials?
What is a Clinical Trial?
A clinical trial gives researchers information about preventing, diagnosing and treating a condition with drugs, procedures, and other options. Patients who participate in clinical trials help create medical advances in:
- Drug therapy
- Proton therapy
- Radiation therapy
- Surgical procedures
Participation in clinical trials is voluntary. Patients enrolled in clinical trials often receive extra care coordination and attention from the clinical trials staff. When patients take part in a clinical trial, they help researchers find better treatments for others in the future, just as today’s patients benefit from the advancements in treatment that were made in past clinical trials.
Cancer care designed around you. And your life.
Learn more about Winship Cancer Institute. Make an appointment online, find a provider or call 404-778-1900 to schedule an appointment.
What Do the Phases of Clinical Trials Mean?
Clinical trials happen in four phases necessary for FDA approval of a new treatment option. Those who enroll in a clinical trial will participate in one of these phases.
Phase I
Phase I clinical trials test new drugs, new combinations of two or more drugs, and devices or procedures. Researchers will determine how safe they are and look into the most effective doses. Side effects will also be tracked.
Phase II
Phase II clinical trials further evaluate the effectiveness and safety of a drug, device, or procedure. Researchers keep track of any medical benefits, as well as side effects.
Phase III
Phase III trials compare a new treatment or procedure with an existing, standard treatment or procedure to determine which works best. Evaluation of side effects and effectiveness continues.
Phase IV
Once a drug or procedure is approved by the U.S. Food and Drug Administration (FDA) and made available to the public, researchers continue to study its safety to figure out the best use of the new treatment.
What Clinical Trials Are Available at the Emory Proton Therapy Center?
Winship Cancer Institute of Emory University
Emory Proton Therapy Center
Cancer care designed around you. And your life.
About Winship Cancer Institute of Emory University
Dedicated to discovering cures for cancer and inspiring hope, Winship Cancer Institute of Emory University is Georgia’s only National Cancer Institute-designated Comprehensive Cancer Center, a prestigious distinction given to the top tier of cancer centers nationwide for making breakthroughs against cancer. Winship is researching, developing, teaching and providing patients novel and highly effective ways to prevent, detect, diagnose, treat and survive cancer. Cancer care at Winship includes leading cancer specialists collaborating across disciplines to tailor treatment plans to each patient’s needs; innovative therapies and clinical trials; comprehensive patient and family support services; and a care experience aimed at easing the burden of cancer. Winship is Where Science Becomes Hope. For more information, visit winshipcancer.emory.edu.
Related Posts
-
Prostate cancer is the second most common cancer among men. Learn its signs and treatments – including proton therapy. -
Learn how proton therapy treats cancerous tumors effectively with potentially fewer side effects. -
Desiree had the rare bone cancer chondrosarcoma, and she needed advanced care. Emory Healthcare delivered expert surgical care.
Recent Posts
-
Dec 11, 2025
-
Dec 8, 2025
-
Dec 3, 2025
-
Nov 17, 2025
-
Nov 14, 2025
-
Nov 10, 2025